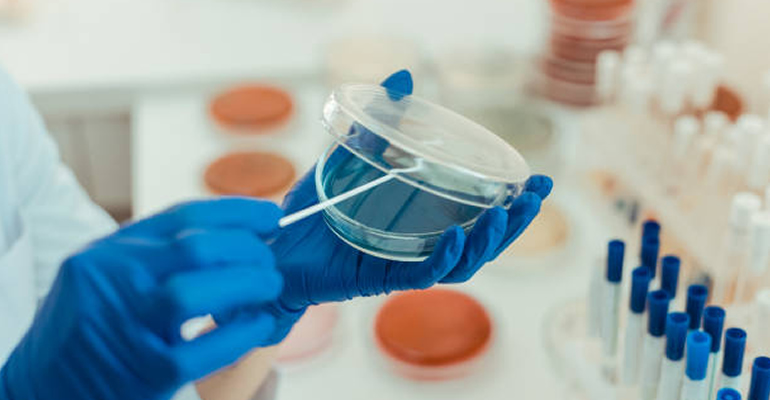

In House Laboratory Auditing
Quality Plus Laboratory Assurance Scheme
Provides an independent validation of your in-house laboratory, using assessors with practical laboratory and food industry experience. Certification of your laboratory signifies that it is efficiently managed with an effective quality system and proven technical competence. It reflects the expertise of your staff and their competency to carry out your analyses.
Do you have a laboratory on site? Then Quality Plus Lab is for you!
Q-Plus is compatible with the principles of International Standards including ISO/IEC 17025 for the general requirements for the competence of testing laboratories. A successful pre-audit of your in-house laboratory will result in a compliance which will provide confidence in your accreditation and analytical results. Contact us today for more information and a Proposal for Implementation and Auditing.
- It is a leader in laboratory testing regionally as a trusted and recognized brand
- We work with experienced auditors and consultants in the food industry
- All our Auditors are approved & calibrated through our Integrity scheme
- Micro consultancy on Laboratory procedures and tests
- Grading in line with GFSI standards